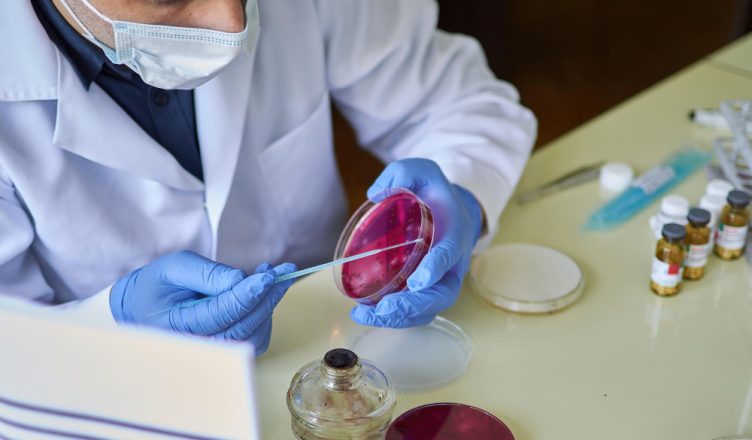

Helicobacter pylori (H. pylori) este o bacterie care poate infecta stomacul uman și duce la diverse afecțiuni gastrointestinale, cum ar fi ulcerul peptic și gastrita. Diagnosticul precis al acestei infecții este esențial pentru a furniza tratamentul adecvat. Unul dintre testele non-invazive folosite pentru detectarea H. pylori este testul respirator pentru Helicobacter pylori. În acest articol, vom explora cum funcționează acest test, când este indicat să fie efectuat și ce implică.
Cum Funcționează Testul Respirator pentru Helicobacter pylori
Testul respirator pentru H. pylori se bazează pe capacitatea bacteriilor H. pylori de a produce o enzimă numită urează. Această enzimă poate converti ureea în dioxid de carbon și amoniac. Testul se efectuează în următorii pași:
1. Administrarea Ureei Etichetate
Pacientul este instruit să înghită o cantitate mică de uree etichetată cu un izotop specific, cum ar fi carbon-13 sau carbon-14. Acest izotop nu este radioactiv și nu prezintă riscuri semnificative pentru sănătate.
2. Colectarea Mostrelor de Aer Expirat
După administrarea ureei etichetate, pacientul va expira într-un sac special la intervale regulate de timp. Aceste mostre de aer expirat conțin dioxid de carbon, care poate fi măsurat și analizat pentru a detecta prezența H. pylori.
3. Reacția Enzimatică
Dacă H. pylori este prezent în stomac, va metaboliza ureea etichetată în dioxid de carbon și amoniac. Dioxidul de carbon eliberat în sânge va fi transportat la plămâni și exhalat în aerul expirat al pacientului.
4. Analiza Mostrelor de Aer
Mostrele de aer expirat sunt colectate și analizate într-un laborator pentru a determina dacă nivelul de dioxid de carbon etichetat este în creștere, ceea ce indică prezența H. pylori.
Indicații pentru Testul Respirator pentru H. pylori
Testul respirator pentru H. pylori este recomandat în următoarele situații:
1. Diagnosticarea Infecției cu H. pylori
Acest test este folosit pentru a confirma prezența bacteriei H. pylori în stomacul pacientului și pentru a stabili diagnosticul de infecție cu H. pylori.
2. Monitorizarea Eficienței Tratamentului
După ce un pacient a fost tratat pentru infecția cu H. pylori, testul respirator poate fi folosit pentru a verifica dacă tratamentul a fost eficient și dacă bacteriile au fost eradicate.
3. Evaluarea Recurenței Infecției
Dacă există suspiciunea că infecția cu H. pylori a reapărut după tratament, acest test poate fi efectuat pentru a confirma prezența bacteriilor.
Avantaje și Dezavantaje ale Testului Respirator pentru H. pylori
Testul respirator pentru H. pylori are câteva avantaje și dezavantaje importante:
Avantaje:
- Este un test non-invaziv, care nu necesită prelevare de sânge sau endoscopie.
- Poate fi efectuat la orice vârstă, inclusiv la copii.
- Este sigur și nu implică expunerea la radiații.
Dezavantaje:
- Poate oferi rezultate false pozitive sau false negative în anumite situații.
- Este necesară cooperarea pacientului în administrarea ureei etichetate și colectarea mostrelor de aer.
Concluzie
Testul respirator pentru Helicobacter pylori este o modalitate non-invazivă și sigură de a detecta prezența bacteriei H. pylori în stomac și de a monitoriza eficiența tratamentului. Este important să discutați cu medicul dumneavoastră despre necesitatea acestui test și să urmați îndrumările medicale pentru diagnosticarea și gestionarea corectă a infecției cu H. pylori. Prin detectarea și tratarea precoce a acestei infecții, puteți preveni complicații gastrointestinale și îmbunătăți calitatea vieții dumneavoastră.